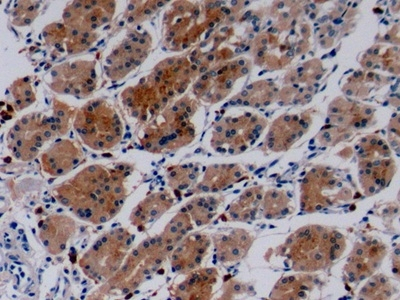
COL4A3 Antibody in Immunohistochemistry (Paraffin) (IHC (P))

Search
Invitrogen
COL4A3 Polyclonal Antibody
{{$productOrderCtrl.translations['antibody.pdp.commerceCard.promotion.promotions']}}
{{$productOrderCtrl.translations['antibody.pdp.commerceCard.promotion.viewpromo']}}
{{$productOrderCtrl.translations['antibody.pdp.commerceCard.promotion.promocode']}}: {{promo.promoCode}} {{promo.promoTitle}} {{promo.promoDescription}}. {{$productOrderCtrl.translations['antibody.pdp.commerceCard.promotion.learnmore']}}
图: 1 / 4
COL4A3 Antibody (PA5149822) in IHC (P)




Please note: We are reviewing Western blot images included in the antibody testing data in our catalog, including those provided by third parties. Unless expressly labeled or annotated as “raw-unedited”, Western blot images included in the antibody testing data in our catalog may have been edited, optimized or otherwise adjusted for presentation.
产品信息
PA5149822
种属反应
宿主/亚型
分类
类型
抗原
偶联物
形式
浓度
规格
纯化类型
保存液
内含物
保存条件
运输条件
RRID
靶标信息
Type IV collagen, the major structural component of basement membranes, is a multimeric protein composed of 3 alpha subunits. These subunits are encoded by 6 different genes, alpha 1 through alpha 6, each of which can form a triple helix structure with 2 other subunits to form type IV collagen. This gene encodes alpha 3. In the Goodpasture syndrome, autoantibodies bind to the collagen molecules in the basement membranes of alveoli and glomeruli. The epitopes that elicit these autoantibodies are localized largely to the non-collagenous C-terminal domain of the protein. A specific kinase phosphorylates amino acids in this same C-terminal region and the expression of this kinase is upregulated during pathogenesis. This gene is also linked to an autosomal recessive form of Alport syndrome. The mutations contributing to this syndrome are also located within the exons that encode this C-terminal region. Like the other members of the type IV collagen gene family, this gene is organized in a head-to-head conformation with another type IV collagen gene so that each gene pair shares a common promoter. [provided by RefSeq, Jun 2010].
仅用于科研。不用于诊断过程。未经明确授权不得转售。
篇参考文献 (0)
生物信息学
蛋白别名: col4a3; collagen alpha-3; Collagen alpha-3(IV) chain; collagen type IV alpha3 chain; Goodpasture antigen; IV chain; procollagen, type IV, alpha 3; tumstatin
基因别名: [a]3(IV); alpha3(IV); COL4A3
UniProt ID: (Mouse) Q9QZS0
Entrez Gene ID: (Mouse) 12828